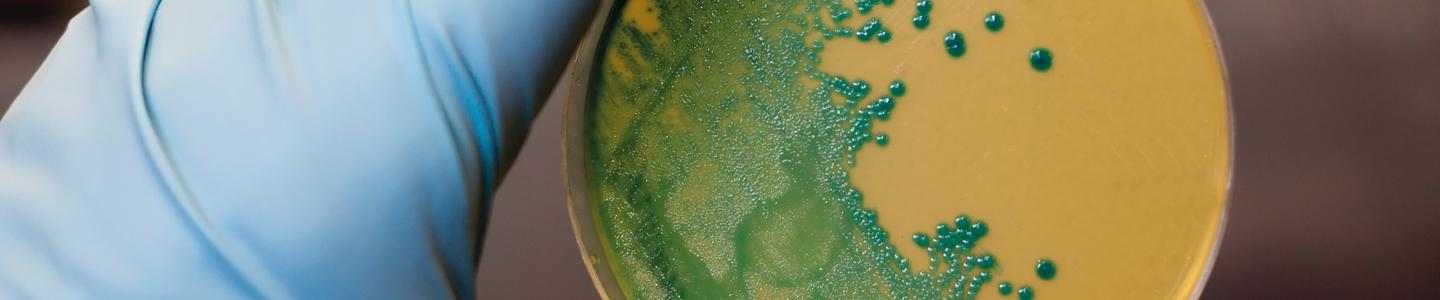
listeria management in processing plants

Listeria poses a significant problem for the food processing industry because of the high proportion of fatal cases in outbreaks. The bacteria can live well and proliferate in conditions where other bacteria can’t. While the optimum temperature for incubation is between 30 to 37 °C, Listeria will grow at temperatures as low as 10°C. As a result, the typical cold food processing environment is favourable for Listeria growth. Additionally, re-contamination after any preservation treatments is still possible due to its ubiquity.
It is extremely likely that Listeria is present in all food processing factories - it may not have been detected yet.
Controlling Listeria is down to prevention. Good manufacturing processes (GMP), HACCP (hazard analysis and critical control points) programmes and good hygienic practices all play a part in mitigating the risk of contamination and controlling Listeria at the processing plant.
On-demand Webinar: Listeria Control During Food Processing
Submit your details to access our on-demand webinar, “Listeria Control During Food Processing”, and learn best practices from our food safety specialists.
Webinar Information
- Webinar recorded during initial broadcast on 24 May 2018, 15:00 CET.
- Approximately 45 minutes duration including Q&A session.
- By registering for the webinar recording you will receive a 50% discount coupon for the Listeria Management course from the Hygiene Academy.
- Webinar will begin after approximately 30 seconds